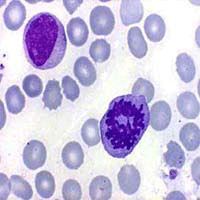

![]() |
|
| Appunti superiori |
|
| Visite: 2683 | Gradito: |
Leggi anche appunti:InfartoInfarto 1 INTRODUZIONE Termine con cui si definisce un La tassonomiaBIOLOGIA La TASSONOMIA è la scienza della classificazione degli organismi Sistemo endocrino ormoniSIST. ENDOCRINO. ORMONI: molecole organiche in una determinata regione dell' organismo |
![]() |
![]() |
LA CELLULA

![]() |
La cellula è la più piccola unità di un organismo in grado di funzionare in modo autonomo. Tutti i viventi sono costituiti da una o più cellule: in base a questa caratteristica, possono essere suddivisi, rispettivamente, in organismi unicellulari e pluricellulari. Al primo gruppo appartengono alghe azzurre, protozoi, alghe e funghi unicellulari; il secondo comprende le piante, gli animali e i funghi, questi organismi pluricellulari però iniziano la loro vita da una sola cellula. La grandezza di un organismo non dipende dalla grandezza delle cellule ma dal loro numero .
La prima osservazione di una cellula al microscopio fu fatta involontariamente da un commerciante di stoffe olandese verso al fine del 1600.
La cellula è normalmente troppo piccola per essere vista. infatti il nostro occhio può a stento
Vedere oggetti con il diametro di 0,1 mm cioè 1/10 di mm. Una cellula, in media ha un diametro circa 10 volte più piccolo, cioè 0,01 mm (1/100 di mm ).
Ogni cellula di animale o pianta è spesso unita ad altre uguali con le quali forma un tessuto.
Pur avendo funzioni e forme diverse le cellule possiedono tutte 4 parti fondamentali:

la membrana citoplasmatica, il citoplasma, la membrana nucleare e il nucleo.

è un sottile rivestimento che avvolge la cellula. Ha la funzione importantissima di regolare lo scambio dei materiali con l'esterno. Essa seleziona con delle "molecole antenna" che sono sulla sua superficie le sostanze che possono attraversarla, escluso l'acqua, l'ossigeno e l'anidride carbonica, che l'attraversano spontaneamente.
Sotto la membrana si trova il citoplasma.
è una sostanza gelatinosa composta prevalentemente da acqua, nella quale sono immerse le strutture della cellula e sono disciolte molte sostanze tra le quali i sali minerali e sostanze organiche.
Nel citoplasma risiedono gli organuli: corpuscoli adibiti alle varie funzioni che la cellula deve svolgere. I più importanti sono:
I mitocondri: sono organuli a forma di fagiolo; essi sono la sede della respirazione cellulare.
Con i mitocondri la cellula respira: l'ossigeno le serve per bruciare le sostanze organiche come gli zuccheri e produrre energia.
I ribosomi: sono a forma di due mezze sfere, hanno la funzione di produrre le proteine, che sono fondamentali per la sopravvivenza della cellula.
I vacuoli: sono piccole vescichette rotonde che contengono un succo :il "succo vacuolare" composto da acqua, sostanze nutritive di riserva e sostanze di rifiuto destinate ad essere espulse dalla cellula
I lisosomi :hanno fora sferica e funzionano come organi difensivi. Essi contengono un acido in grado di demolire qualsiasi sostanza come batteri e particelle estranee che penetrano all'interno della cellula. Sono chiamati "sacchi suicidi" perché in alcune circostanze si rompono e autodistruggono la cellula
Il reticolo endoplasmatico: è una fitta rete di canali e vescichette comunicanti tra loro, attraverso la quale le sostanze vengono trasportate e depositate da un punto all'altro della cellula.
L'apparato del Golgi: è cosi' detto dal nome del medico italiano CAMILLO GOLGI che lo notò per primo. E' costituito da una serie di sacchetti schiacciati e impilati; ogni sacchetto si rigonfia in vescicole che si staccano e si allontanano trasportando all'esterno le sostanze prodotte dalla cellula e necessarie all'organismo.
I centrioli: hanno forma cilindrica e hanno un'importante funzione nella riproduzione cellulare.
L A MENBRANA CELLULARE
La cellula è formata
per circa il 70% di acqua e da solo 30% di sostanze organiche.
IL PASSAGGIO DI SOSTANZE ORGANICHE attraverso la membrana cellulare non è
stabile ma può variare a seconda delle sostanze.
IL TRASPORTO PASSIVO si verifica per diffusione di una sostanza all'interno della
La membrana cellulare o
plasmatica è l'involucro della cellula.
E' costituita da un doppio strato continuo di molecole di fosfolipidi, dello
spessore di 8-10 nm (un nanometro corrisponde a un miliardesimo di metro),
attraversata parzialmente o completamente da numerose proteine. I fosfolipidi
sono particolari grassi formati da una' testa' di glicerolo ed una
coda lipidica.
Nella cellula la membrana oltre alle funzioni protettive si comporta da filtro
facendo passare solo le sostanze utili.

È un rivestimento che racchiude il nucleo. presenta numerose aperture attraverso le quali le sostanze passano nel citoplasma.
E' la parte centrale e più importante della cellula e ne rappresenta il cervello.
Rappresenta il 6% del volume cellulare. E' avvolto in una doppia membrana, interrotta da pori. Provvede alla riproduzione della cellula ed è il centro direttivo perché contiene il DNA combinato con proteine.
CROMOSOMI

Nei cromosomi è insito il genoma della cellula. Nel nucleo avviene la duplicazione del DNA e la sua trascrizione .
Quando la cellula comincia a dividersi, si nota che il nucleo è formato da tanti piccoli bastoncelli strutture filamentose ancora indistinte che rappresentano i cromosomi.
Se si
ordinano questi bastoncelli in base alla loro lunghezza e si dispongono su di
un piano, si vede che in ogni cellula ce ne sono 46, uguali due a due,
organizzabili quindi in 23coppie.
L'insieme dei cromosomi così ordinati costituisce la mappa cromosomica.
Nella mappa cromosomica ci sono quindi 23 coppie di cromosomi. Le prime 22
coppie sono formate da cromosomi uguali mentre la 23° coppia presenta delle
diversità a seconda che si tratti di un maschio o di una femmina. Più
precisamente nella femmina la 23° coppia è costituita da due cromosomi identici
denominati XX. Nel maschio la 23° coppia è costituita invece da due cromosomi
diversi uno più grande, il cromosoma X, ed uno molto più piccolo denominato
Y.Dato che a questi due cromosomi sono collegati i caratteri distintivi dei due
sessi, la 23°coppia viene denominata coppia dei cromosomi del sesso.
I cromosomi sono uguali due a due perché uno è di derivazione paterna ed uno di
derivazione materna, in ogni cromosoma di una coppia sono quindi contenute le
stesse informazioni cioè gli stessi geni.
I cromosomi sono costituiti da DNA che è una sostanza chimica la cui struttura
ricorda quella di una scala con i due montanti ed i gradini, ma che non è
visibile al microscopio. Siccome è una struttura molto lunga, avvolgendosi su
se stessa diverse volte si accorcia e si ispessisce fino a divenire visibile
appunto sotto forma di cromosomi. Quando la cellula non si divide i cromosomi
sono fortemente compattati tanto da dare l'impressione di essere una unica
masserella che è appunto il nucleo delle cellule.
![]() |
Le cellule vegetali, per attuare la fotosintesi (processo che permette
di trasformare energia solare in energia chimica), possiedono degli organuli
citoplasmatici detti cloroplasti. I
cloroplasti sono in pratica un insieme di membrane La struttura di base della
membrana cellulare è costituita da un doppio
strato fosfolipidico, ossia un doppio strato di molecole fosfolipidiche
disposte con le loro code idrofobe di acidi grassi verso l'interno. Questa
struttura permette di formare una membrana
selettivamente permeabile, cioè che permette il passaggio di alcune
sostanze, mentre impedisce il passaggio di altre.
La membrana cellulare contiene, però, anche numerose molecole proteiche sospese
nel doppio strato lipidico che partecipano al trasporto di sostanze attraverso
la membrana.
organizzate in pile di tilacoidi che possiedono clorofilla.
Invece, praticamente in tutte le cellule sono presenti i mitocondri, organuli che permettono di attuare la respirazione
cellulare, processo in cui si trasforma energia chimica in energia fruibile
dalla cellula.
Le cellule vengono suddivise in due tipi fondamentali: cellule PROCARIOTE e
cellule EUCARIOTE
La cellula procariote sono le cellule dei batteri, sono proprie degli organismi unicellulari e sono molto più piccole ( anche la centesima parte ) delle eucariote. Sono prive di organuli e il nucleo è immerso direttamente nel citoplasma.

Dfdfgggg

xxcxccv
La cellula eucariote è quella a cui ci si riferisce, quando si parla di cellula ed è molto più grande e complessa della cellula procariote.
Sia negli animali che nelle piante, le cellule sono molto diverse tra loro e la loro forma è
Ci
sono tanti tipi di cellule: CELLULA NERVOSA

legata alla funzione che devono svolgere.
Ci sono vari tipi di cellule: di trasporto ( es. nel sangue e nella linfa ), di sostegno ( es. nelle ossa e nella corteccia ), elastiche ( es. nei muscoli ), messaggere ( es. nei nervi ).
In un organismo, non tutte le cellule hanno la stessa durata di vita; ad esempio in un corpo umano le cellule della pelle vivono in media per 20 giorni, quelle dell'intestino 7 giorni, i globuli rossi 120 giorni, i globuli bianchi 2 giorni e le cellule muscolari per tutta la vita.
Un vantaggio degli organismi pluricellulari è che la morte di una cellula non provoca la morte dell'organismo.
Si è calcolato che ogni giorno nel nostro corpo muoiono circa 100 milioni di cellule.
Un esempio di cellule morte è la forfora che si trova sugli strati superficiali della pelle.
Quando la cellula esaurisce le sue funzioni, l'RNA messaggero invia il messaggio al DNA che riproduce una cellula identica.
Il ciclo cellulare è composto fondamentalmente da due parti: l'interfase e la mitosi. L'interfase è essenzialmente un periodo di sintesi, infatti è costituita da una fase G1 in cui vengono sintetizzati tutti i componenti cellulari, una fase S in cui viene duplicato il materiale genetico e una fase G2 in cui vengono sintetizzati tutti i materiali necessari alla successiva mitosi. La mitosi, invece è il processo che permette la formazione di due cellule figlie da una cellula madre con una equa e precisa ripartizione del materiale genetico che pertanto risulta identico nelle due cellule figlie ed identico a quello della cellula madre. Il processo mitotico è costituito da 4 fasi:
Profase: la cromatina comincia a compattarsi per formare i cromosomi, scompare il nucleolo e comincia la formazione del fuso mitotico
Metafase: scompare l'involucro nucleare, il fuso occupa l'intera cellula da un polo all'altro e i cromosomi, che in questo stadio hanno raggiunto il massimo grado di compattazione, migrano verso il centro della cellula a formare la piastra equatoriale.

Anafase: i cromosomi, legati ai microtubuli mediante il cinetocore, vengono tirati verso i poli in modo che ciascun cromatide migri verso il polo opposto della cellula.

Telofase: i cromatidi costituiscono due gruppi separati ai poli cellulari e comincia la loro despiralizzazione. Il fuso viene degradato e comincia la formazione delle due nuove membrane nucleari intorno ai due gruppi di cromatidi che rappresentano il corredo cromosomico delle due cellule figlie, le quali cominciano a delinearsi per la formazione di una strozzatura al centro della cellula.
A questo punto la cellula può dividersi e le due cellule figlie si ritrovano in fase G1.
Un insieme di
cellule altamente organizzato forma un Tessuto; gli elementi cellulari che
compongono un determinato tessuto sono simili tra loro sia per la forma che per
la struttura ed hanno il compito di espletare la stessa funzione.
I tessuti possono essere classificati in 4 grandi gruppi:
1. Tessuti Epiteliali o di Rivestimento;
2. Tessuti Muscolari;
3. Tessuti Connettivi;
4. Tessuti Nervosi.
La cute e le mucose che tappezzano le cavità interne fanno parte dei tessuti
epiteliali, così come le ghiandole che sono composte da cellule epiteliali con
capacità secretive.
I tessuti muscolari sono i componenti fondamentali della muscolatura, che può
essere, in funzione delle fibre componenti e della specifica funzione, liscia,
striata e miocardica. La caratteristica delle cellule muscolari sono le
Miofibrille, formazioni che riescono a trasformare l'energia chimica in energia
cinetica generando movimento.
Globuli rossi
I tessuti Connettivi sono tessuti di
riempimento e di sostegno, ne fanno parte il T. Osseo, il T. Cartilagineo, la
parte fibrosa dei vasi sanguigni ed il Sangue.
La caratteristica di questi tessuti è la presenza di una sostanza
intercellulare (matrice) che può essere più o meno fluida e che ha la proprietà
di conferire maggior resistenza al tessuto; ad esempio nel tessuto osseo la
matrice è rappresentata dai sali di Calcio, che conferiscono durezza e
resistenza alle ossa; nel sangue la matrice è il Plasma, la cui fluidità
conferisce le capacità di scorrimento e di trasporto tipiche del Sangue.
TESSUTO NERVOSO
Il Tessuto Nervoso è un tessuto composto da cellule ad alta differenziazione con caratteristiche talmente particolari che né fanno il tessuto nobile del corpo umano, in quanto dai suoi 'terminali' partono tutte le informazioni che ci consentono di vivere e che, come vedremo successivamente, rappresentano anche un cardine sul mantenimento di alcune funzioni fisiologiche di adattamento nel corso dell'immersione in Apnea
ORGANI APPARATI
Un insieme di più tessuti ordinati danno origine ad un Organo, struttura più
complessa con caratteristiche anatomiche ben definite e funzioni altamente
specializzate.
Ad esempio una ghiandola presenta una componente di tessuto epiteliale (parte
secernente) compresa in una trama di tessuto connettivo attraversati entrambi
da vasi nutritizi.
Più organi destinati alla medesima funzione formano un apparato ( ad esempio:
l'insieme di vene, arterie e cuore che formano l'apparato Cardiocircolatorio).
![]() |
| Appunti su: xxcxccv, ricera scienze La Cellula, |
|